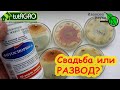

СЕМЕНА ИМЕЮТ ХВОЩИ МХИ ПАПОРОТНИКИ ЦВЕТКОВЫЕ
В мире растений существует множество видов, которые размножаются при помощи семян. В этой статье мы рассмотрим особенности размножения хвощей, мхов, папоротников и цветковых растений с помощью семян.
Хвощи - это растения, которые относятся к отряду хвощевых. Они имеют уникальную особенность - своего рода "живые" семена. У хвощей семена покрыты специальными клетками, содержащими много животных белков. Благодаря этому они могут передвигаться и рассеиваться независимо. Когда условия становятся благоприятными, хвощики начинают прорастать из семян, чтобы дать жизнь новым растениям.
Мхи - это небольшие растения, которые также размножаются при помощи семян. В отличие от хвощей, у них семена не обладают подвижностью. Вместо этого мхи осваивают новую территорию с помощью спороносных стеблей, которые производят споры. Споры призваны обеспечить передвижение мхов и их размножение. Попадая на удобную почву, споры прорастают и превращаются в новые мхи.
Папоротники - это растения с крупными листьями, которые тоже размножаются с помощью семян. Папоротники обладают особыми структурами, называемыми спорангиями, в которых формируются споры. Споры являются главным источником размножения папоротников. Они рассеиваются в окружающую среду, и если попадают на благоприятную почву, начинают прорастать и превращаются в новые растения.
Цветковые растения - самая многочисленная группа семенных растений. Семена цветковых растений образуются после опыления цветков, когда пыльца попадает на пестики. Оплодотворенные пестики превращаются в плоды, в которых зреют семена. Разнообразие цветковых растений впечатляет своими формами, цветами и ароматами, и они являются основными представителями растительного мира.
Споровые растения (мхи, хвощи, плауны, папоротники) - Биология ЦТ, ЕГЭ
Мхи, папоротники, водоросли
Очарование, красота и восторг - экзакум, от посева до цветения
Биология - Общая характеристика мхов. Мхи и лишайники
Картинка и реальность. Что выросло из семян цветов в 2022? Однолетники из семян.
Покрытосеменные и голосеменные - ЖИЗНЕННЫЕ ЦИКЛЫ растений
Несколько основных правил для успешного выращивания эустомы